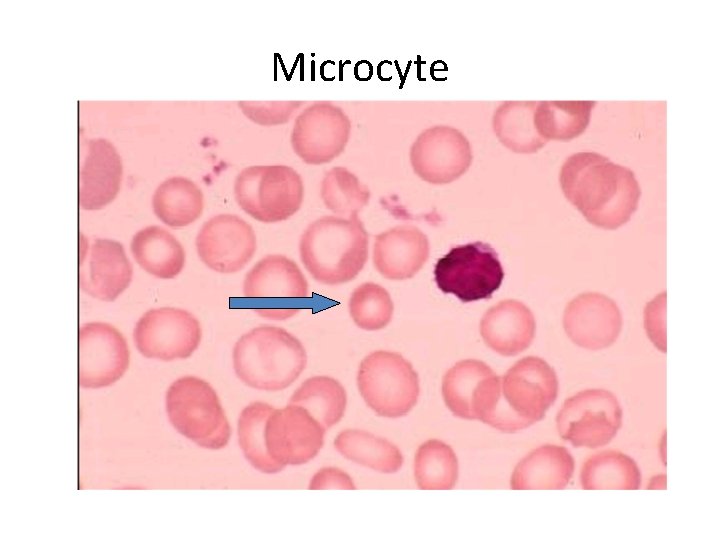
Microcyte
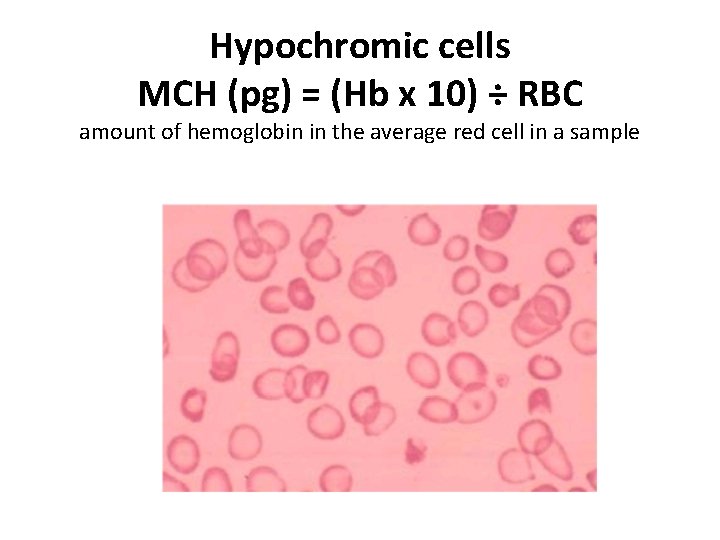
Hypochromic cells MCH (pg) = (Hb x 10) ÷ RBC amount of hemoglobin in
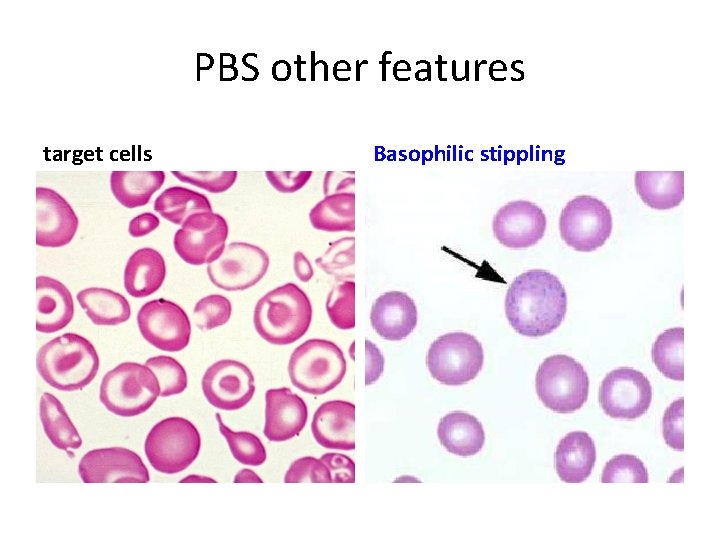
PBS other features target cells Basophilic stippling

thalassemia Dr ajit nambiar objectives Definition Cause genetics

thalassemia Dr ajit nambiar

objectives • • • Definition Cause genetics Classification Clinical features Blood picture

3

definition • Prototypic example of hemolytic anemia • Caused by a decreased rate or absence of synthesis of certain haemoglobins

Haemoglobin dimer Hb consists of 4 globin chains (2 pairs) each chain with a haeme group. 5

A: 96 -98% A 2: 1. 5 -3. 2% F: 0. 5 -1% 6

Thalassaemias • Thalassaemia is a genetic disorder (autosomal recessive) • Causes a decreased rate or absence of synthesis of certain haemoglobins (mainly alpha and Beta) • Leading to an imbalance of globin chains available for hemoglobin dimer construction. • This results in the formation of abnormal amounts of structurally normal (normal amino acid sequence) hemoglobins. • Unbalanced Alpha/Beta chain ratio leading to ineffective erythropoiesis 7

Thalassaemia Genetics Types of genetic abnormalities: • Mutations(point mutations) leading to loss of gene expression: Most common form in Beta-thalassaemia. • Loss of genetic material i. e. deletions: Most common form in Alpha-thalassaemia. 8

Broad classification • Beta thalassemia • Alpha thalassemia And • Trait • disease

If you have thalassemia trait, YOU DO NOT HAVE THE DISEASE. However, there is a possibility that your children could have thalassemia disease.

Beta Thalassaemia Clinical syndromes: • Thalassaemia minor: Heterozygous : B 0/B no or mild anaemia but microcytosis and hypochromia • Thalassaemia Major: Homozygous : B 0/B 0 Severe anaemia and transfusion dependancy 11

BETA THALASSEMIA MAJOR

consequences

14

Hair on end appearance Thalassaemia faces 15
Microcyte
Hypochromic cells MCH (pg) = (Hb x 10) ÷ RBC amount of hemoglobin in the average red cell in a sample
PBS other features target cells Basophilic stippling

Beta-Thalassaemia major • • • Severe anaemia becomes apparent at 3 6 months after birth when the switch from gamma to beta production should take place. Enlargement of the liver and spleen occurs as a result of excessive red cell destruction, extramedullary haemopoiesis and later because of iron overload. Prone for infections. Pneumococcal, Hemophilus and meningococcal infections are likely if splenectomy has been carried out and prophylactic penicillin is not taken. Transfusion of viruses by blood transfusion may occur especially HBV, HCV and HIV if necessary precautions are not taken. • • Expansion of bones caused by intense marrow hyperplasia leads to a thalassaemic facies and to thinning of the cortex of many bones with a tendency to fractures and bossing of the skull with a 'hair-on-end' appearance on X ray. The patient can be sustained by blood transfusions but iron overload caused by repeated transfusions is inevitable unless chelation therapy is given. Organ failure (cardiomyopathy, liver cirrhosis, endocrine dysfunction like DM).

Beta Thal. Lab diagnosis Features • Microcytic hypochromic anaemia at age of 6 months • raised reticulocyte percentage with normoblasts, target cells' and basophilic stippling in theblood film • Haemoglobin electrophoresis reveals High Hb-F, High Hb. A 2, No or low Hb-A • Assessment of iron status • - serum ferritin is the most widely used test. • - Bone marrow biopsy (Perls' stain) for reticuloendothelial stores 20

Hemoglobin electrophoresis A (α 2β 2): 96 -98% A 2 (α 2δ 2): 1. 5 -3. 2% F( α 2 γ 2): 0. 5 -1%

Beta Thal. Management: Prevention Adequate and safe transfusion Iron chelation Comprehensive care 22

Thalassemia minor • This is a common, usually symptomless, abnormality characterized like a thalassaemia trait by a hypochromic, microcytic blood picture (MCV and MCH very low) and mild anaemia (haemoglobin 10 12 g/d. L). • A raised Hb A 2 (>3. 5%) confirms the diagnosis.

Important indication for making diagnosis • allows the possibility of prenatal counselling to patients with a partner who also has a significant haemoglobin disorder. • If both carry β thalassaemia trait there is a 25% risk of a thalassaemia major child.

ALPHA THALASSEMIA

Alpha Thalassaemia • • Reduced alpha globin chain production 4 Alpha genes so complex inheritance and many possibilities 26

Alpha Thalassaemia Types: • If 1 gene deleted : aa/a- : Silent or carrier type T • If 2 genes deleted (a/a 0 or a+/a+): alpha thal. trait but microcytosis and hypochromia • If 3 genes deleted: Hb. H disease: (4 beta chains): -a/-- : moderate to severe anaemia • If 4 genes deleted: hydrops foetalis (Hb-Barts: 4 gamma chains): --/-- 27

HYDROPS FETALIS Hydrops fetalis usually stems from fetal anemia, when the heart needs to pump a much greater volume of blood to deliver the same amount of oxygen. The increased demand for cardiac output leads to heart failure, and corresponding edema. abnormal accumulation of fluid in 2 or more fetal compartments, including ascites, pleural / pericardial effusion, and skin edema. The condition is incompatible with life beyond the fetal stage. Immune: Rh incompatilibility Non. Immune: Thalassemia

Thalassemia carry home message • Remember to investigate anemia cases (prevention) • Remember beta thalassemia major show increased risk of periodontal disease, dental caries and malocclusion. • Blood picture

Any questions ? ? ? THANK U
- Slides: 30